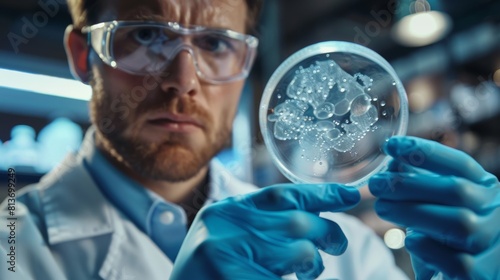

Download sample
File Details
Published: 2024-05-13 13:32:05.366332 Category: People Type: Illustration Model release: NoShare
Scientist holding cold petri dish with samples in a busy modern laboratory.
Contributor: Антон Сальников
ID : 813699249
